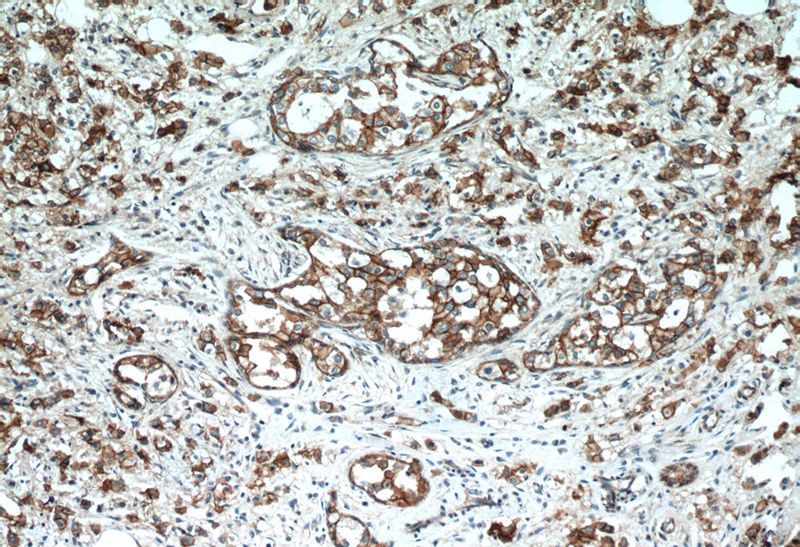
Immunohistochemistry of paraffin-embedded human breast cancer tissue slide using Catalog No:117132(B-catenin Antibody) at dilution of 1:200 (under 10x lens)
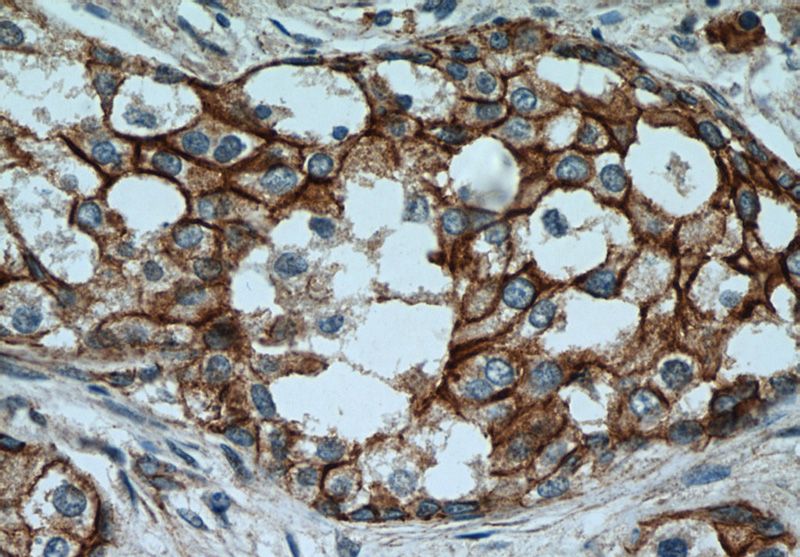
Immunohistochemistry of paraffin-embedded human breast cancer tissue slide using Catalog No:117132(B-catenin Antibody) at dilution of 1:200 (under 40x lens)

-
Product Name
beta-Catenin antibody
- Documents
-
Description
beta-Catenin Rabbit Polyclonal antibody. Positive IHC detected in human breast cancer tissue, human cervical cancer tissue, human colon cancer tissue, human liver cancer tissue, human stomach cancer tissue. Positive IF detected in HepG2 cells. Positive WB detected in mouse lung tissue, A431 cells, HEK-293 cells, HeLa cells, human placenta tissue, MCF7 cells, mouse liver tissue, NIH/3T3 cells, rat liver tissue, SH-SY5Y cells. Positive IP detected in mouse liver tissue. Observed molecular weight by Western-blot: 90 kDa
-
Tested applications
ELISA, IF, WB, IHC, IP
-
Species reactivity
Human, Mouse,Rat,Pig; other species not tested.
-
Alternative names
b cat antibody; Beta catenin antibody; beta-Catenin antibody; Catenin beta 1 antibody; CTNNB antibody; CTNNB1 antibody; DKFZp686D02253 antibody; FLJ25606 antibody; FLJ37923 antibody; PRO2286 antibody; β catenin antibody; β-catenin antibody
-
Isotype
Rabbit IgG
-
Preparation
This antibody was obtained by immunization of Peptide (Accession Number: XM_047447479). Purification method: Antigen affinity purified.
-
Clonality
Polyclonal
-
Formulation
PBS with 0.02% sodium azide and 50% glycerol pH 7.3.
-
Storage instructions
Store at -20℃. DO NOT ALIQUOT
-
Applications
Recommended Dilution:
WB: 1:500-1:5000
IP: 1:200-1:2000
IHC: 1:20-1:200
IF: 1:20-1:200
-
Validations

Immunofluorescent analysis of HepG2 cells, using CTNNB1 antibody Catalog No:117132 at 1:50 dilution and Rhodamine-labeled goat anti-rabbit IgG (red). Blue pseudocolor = DAPI (fluorescent DNA dye).
Immunohistochemistry of paraffin-embedded human breast cancer tissue slide using Catalog No:117132(B-catenin Antibody) at dilution of 1:200 (under 10x lens)
Immunohistochemistry of paraffin-embedded human breast cancer tissue slide using Catalog No:117132(B-catenin Antibody) at dilution of 1:200 (under 40x lens)

mouse lung tissue were subjected to SDS PAGE followed by western blot with Catalog No:117132(b-cat antibody) at dilution of 1:1000

IP Result of anti-B-catenin (IP:Catalog No:117132, 4ug; Detection:Catalog No:117132 1:500) with mouse liver tissue lysate 6400ug.
-
Background
β-Catenin is an evolutionarily conserved, multifunctional intracellular protein. β-Catenin was originally identified in cell adherens junctions (AJs) where it functions to bridge the cytoplasmic domain of cadherins to a-catenin and the actin cytoskeleton. Besides its essential role in the AJs, β-catenin is also a key downstream component of the canonical Wnt pathway that plays diverse and critical roles in embryonic development and adult tissue homeostasis. Deregulation of β-catenin activity is associated with multiple diseases including cancers. (PMID: 22617422; 18334222)
-
References
- Zhang F, Chen A, Chen J, Yu T, Guo F. Influence of β-catenin small interfering RNA on human osteosarcoma cells. Journal of Huazhong University of Science and Technology. Medical sciences = Hua zhong ke ji da xue xue bao. Yi xue Ying De wen ban = Huazhong keji daxue xuebao. Yixue Yingdewen ban. 31(3):353-8. 2011.
- Zhang F, Chen A, Chen J, Yu T, Guo F. SiRNA-mediated silencing of beta-catenin suppresses invasion and chemosensitivity to doxorubicin in MG-63 osteosarcoma cells. Asian Pacific journal of cancer prevention : APJCP. 12(1):239-45. 2011.
- Song Y, Xue L, Du S. Caveolin-1 knockdown is associated with the metastasis and proliferation of human lung cancer cell line NCI-H460. Biomedicine & pharmacotherapy = Biomédecine & pharmacothérapie. 66(6):439-47. 2012.
- Okai I, Wang L, Gong L. Overexpression of JAKMIP1 associates with Wnt/β-catenin pathway activation and promotes cancer cell proliferation in vitro. Biomedicine & pharmacotherapy = Biomédecine & pharmacothérapie. 67(3):228-34. 2013.
- Ning Q, Liu C, Hou L. Vascular endothelial growth factor receptor-1 activation promotes migration and invasion of breast cancer cells through epithelial-mesenchymal transition. PloS one. 8(6):e65217. 2013.
- Luo Y, Sun Z, Li Y, Liu L, Cai X, Li Z. Caudatin inhibits human hepatoma cell growth and metastasis through modulation of the Wnt/β-catenin pathway. Oncology reports. 30(6):2923-8. 2013.
- Zeng L, Wang W, Rong XF. Chondroprotective effects and multi-target mechanisms of Icariin in IL-1 beta-induced human SW 1353 chondrosarcoma cells and a rat osteoarthritis model. International immunopharmacology. 18(1):175-81. 2014.
- Miao L, Xiong X, Lin Y. miR-203 inhibits tumor cell migration and invasion via caveolin-1 in pancreatic cancer cells. Oncology letters. 7(3):658-662. 2014.
Related Products / Services
Please note: All products are "FOR RESEARCH USE ONLY AND ARE NOT INTENDED FOR DIAGNOSTIC OR THERAPEUTIC USE"
